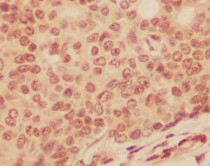

ARG42709
anti-4E-BP1 antibody
anti-4E-BP1 antibody for Flow cytometry,ICC/IF,IHC-Formalin-fixed paraffin-embedded sections,Immunoprecipitation,Western blot and Human,Mouse,Rat
Overview
| Product Description | Rabbit Polyclonal antibody recognizes 4E-BP1 |
|---|---|
| Tested Reactivity | Hu, Ms, Rat |
| Tested Application | FACS, ICC/IF, IHC-P, IP, WB |
| Host | Rabbit |
| Clonality | Polyclonal |
| Isotype | IgG |
| Target Name | 4E-BP1 |
| Antigen Species | Human |
| Immunogen | Synthetic peptide derived from Human 4E-BP1. |
| Conjugation | Un-conjugated |
| Alternate Names | Phosphorylated heat- and acid-stable protein regulated by insulin 1; eIF4E-binding protein 1; PHAS-I; Eukaryotic translation initiation factor 4E-binding protein 1; 4EBP1; 4E-BP1; BP-1 |
Application Instructions
| Application Suggestion |
|
||||||||||||
|---|---|---|---|---|---|---|---|---|---|---|---|---|---|
| Application Note | * The dilutions indicate recommended starting dilutions and the optimal dilutions or concentrations should be determined by the scientist. |
Properties
| Form | Liquid |
|---|---|
| Purification | Affinity purified. |
| Buffer | PBS (pH 7.4), 150 mM NaCl, 0.02% Sodium azide and 50% Glycerol. |
| Preservative | 0.02% Sodium azide |
| Stabilizer | 50% Glycerol |
| Storage Instruction | For continuous use, store undiluted antibody at 2-8°C for up to a week. For long-term storage, aliquot and store at -20°C. Storage in frost free freezers is not recommended. Avoid repeated freeze/thaw cycles. Suggest spin the vial prior to opening. The antibody solution should be gently mixed before use. |
| Note | For laboratory research only, not for drug, diagnostic or other use. |
Bioinformation
| Database Links | |
|---|---|
| Gene Symbol | EIF4EBP1 |
| Gene Full Name | eukaryotic translation initiation factor 4E binding protein 1 |
| Background | This gene encodes one member of a family of translation repressor proteins. The protein directly interacts with eukaryotic translation initiation factor 4E (eIF4E), which is a limiting component of the multisubunit complex that recruits 40S ribosomal subunits to the 5' end of mRNAs. Interaction of this protein with eIF4E inhibits complex assembly and represses translation. This protein is phosphorylated in response to various signals including UV irradiation and insulin signaling, resulting in its dissociation from eIF4E and activation of mRNA translation. [provided by RefSeq, Jul 2008] |
| Function | Repressor of translation initiation that regulates EIF4E activity by preventing its assembly into the eIF4F complex: hypophosphorylated form competes with EIF4G1/EIF4G3 and strongly binds to EIF4E, leading to repress translation. In contrast, hyperphosphorylated form dissociates from EIF4E, allowing interaction between EIF4G1/EIF4G3 and EIF4E, leading to initiation of translation. Mediates the regulation of protein translation by hormones, growth factors and other stimuli that signal through the MAP kinase and mTORC1 pathways. [UniProt] |
| Calculated MW | 13 kDa |
| PTM | Phosphorylated on serine and threonine residues in response to insulin, EGF and PDGF. Phosphorylation at Thr-37, Thr-46, Ser-65 and Thr-70, corresponding to the hyperphosphorylated form, is regulated by mTORC1 and abolishes binding to EIF4E. Ubiquitinated: when eIF4E levels are low, hypophosphorylated form is ubiquitinated by the BCR(KLHL25) complex, leading to its degradation and serving as a homeostatic mechanism to maintain translation and prevent eIF4E inhibition when eIF4E levels are low. Not ubiquitinated when hyperphosphorylated (at Thr-37, Thr-46, Ser-65 and Thr-70) or associated with eIF4E. [UniProt] |
Images (3) Click the Picture to Zoom In
-
ARG42709 anti-4E-BP1 antibody ICC/IF image
Immunofluorescence: HeLa cells stained with ARG42709 anti-4E-BP1 antibody (green).
-
ARG42709 anti-4E-BP1 antibody IHC-P image
Immunohistochemistry: Paraffin-embedded Human breast carcinoma tissue stained with ARG42709 anti-4E-BP1 antibody.
-
ARG42709 anti-4E-BP1 antibody WB image
Western blot: K562 cell lysate stained with ARG42709 anti-4E-BP1 antibody.